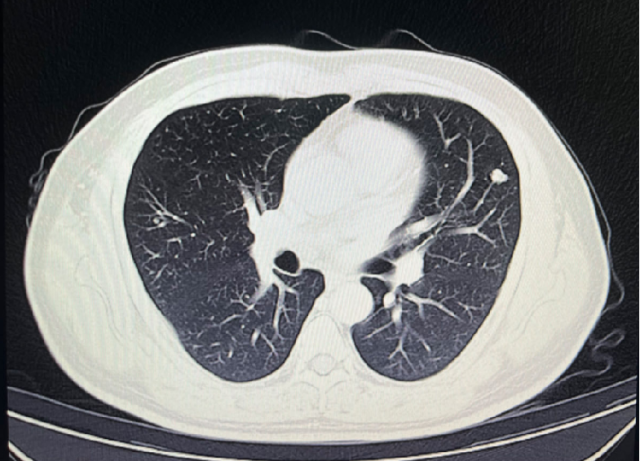
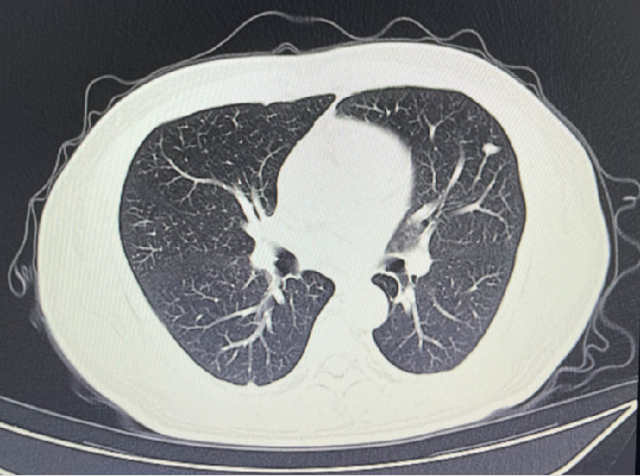
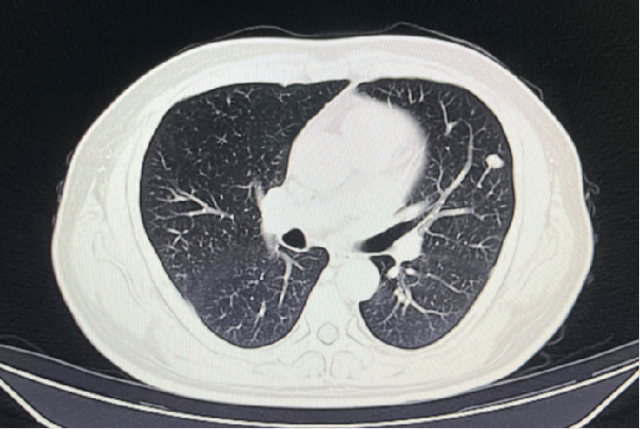

患者:贾XX,男,39 岁。
主诉:左肾癌术后 2 年余。
现病史:患者于 2 年余因血尿至郑大一附院就诊,经完善检查诊断为「左肾肿瘤」,后于 2020 年 8 月 28 日行全麻下行「腹腔镜左肾根治性切除术」,术后病理示:(左肾切除标本)肾细胞癌,结合形态及免疫组化,较符合乳头状肾细胞癌,II 型。术后口服「培唑帕尼」治疗,10 个月后因腹泻、高血压,自行停药。复查 CT 示:左肺上极及右肺中叶小结节,左肺上极小结节较前密度稍高。今为进一步治疗来我院就诊,门诊以「左肾癌术后腹膜后淋巴结转移」为诊断收入院。
既往史、个人史、家族史:均余无特殊。



诊断
考虑为:左肾癌术后肺转移(T1N1M1)
T1:术前肿瘤最大径 3cm
N1:肾门淋巴结阳性
M1:左肺结节
病人暂不考虑手术切除肺部病灶
双肺多发结节
可疑结节直径较小
给予阿昔替尼联合特瑞普利单抗治疗
影像学检查
2023-05-03:

2023-08-01:


2023-11-08:

2024-02-28:


2024-05-17:

治疗方案变更
靶免联合治疗期间
出现蛋白尿(2023.08)
手足综合征及高血压
更换为伏罗尼布继续治疗(2024.05)
治疗过程

问题探讨
1. 靶免联合治疗期间出现蛋白尿(2023.08)
是否需减量或停药?
长期蛋白尿是否影响肾功能?是否是较为严重的问题?
2. 病情稳定近两年(2022.08-2024.05)
能否停用 TKI,单用免疫维持?
复查 PET-CT 后,肺部单发病灶放疗?
